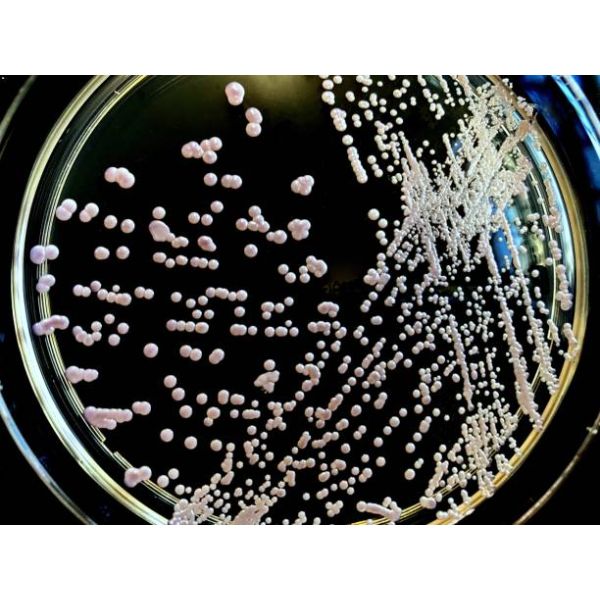
Yeast Culture Supply: Free

Order before 2pm for UK next day shipping | US | EXPORT
Yeast Culture Supply: Free
Freeze-Dried Ampoule
Availability:
Out of stock
SKU
LAB-YEAST-CULT-FREE
| Vegan | No |
|---|
Need technical advice?
Find all the your TDS and SDS here.
Talk to the people in the know by calling one of our qualified brewers and winemakers on 0115 978 5494




Murphy & Son, Alpine Street, Old Basford, Nottingham, NG6 0HQ, United Kingdom.
Murphy & Son Ltd | 0115 978 5494 | Legal Pages